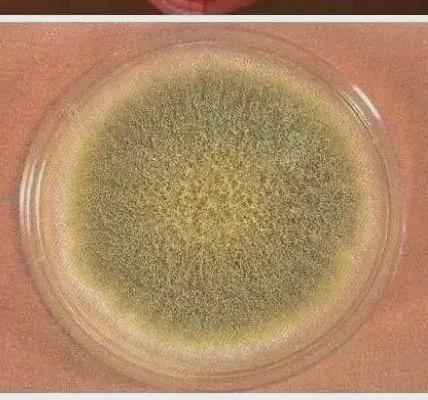

炸锅啦!浙大研究颠覆北方生活习惯:冷冻馒头2天生毒素,不能吃
时间:2024-12-03 22:08
分类:阿凫爱吐槽
11月11日,浙江大学发表了一个研究的发现:馒头在室温条件下,储存超过一天就会生长出霉菌。
即便是在冷冻的条件,霉菌也会缓慢地滋长。特别是在拿出来解冻的过程中,霉菌迅速生长。
馒头冷冻超过两天后,就不能吃了。所以研究人员建议,以后买馒头的时候,买够当天吃完的量就行,不要买太多。

馒头滋生的霉菌叫黄曲霉素,它的毒性很强,远高于氰化物、砷化物和有机农药的毒性。
如果人体摄入大量的黄曲霉素,可发生急性中毒,出现急性肝炎、出血性坏死、肝细胞脂肪变性和胆管增生。
如果只是微量持续摄入,也会造成慢性中毒,生长障碍,引起纤维性病变,致使纤维组织增生。
它的致癌性非常强,可以算是数一数二的级别。

可以这么说,这个研究结果,有点颠覆我们生活的习惯,或具体来说,有点颠覆北方朋友们的平常生活习惯。
馒头是北方许多地区的主食,有些家庭习惯于买几天的量,放冰箱里面留着。尤其是冬天,家里面做馒头的话,也不太可能只做一天的量,一般都是一次性做好多天的。等要吃了再加热。
或许有人疑惑高温不是可以杀死霉菌吗,解冻后重新蒸了应该没事了吧?
还真不行。
高温可以杀死细菌,但黄曲霉素不是细菌,它能耐高温,在一般加热条件下,很难杀死它,需要在超高温高压条件下,才能使它灭活。

看完这里,以后我们当天吃不完馒头,是不是要丢掉,我们还敢吃隔天的馒头吗?
“以后速冻饺子还能吃吗?”
我看了一下评论区,网友们炸锅了。
但大家不是害怕以后再也不能吃冷冻馒头,而更多的是质疑这个研究。
“都吃了那么多年了,在没有冰箱的年代,就算发霉了,照样吃!”
“岳母天天吃加热的馒头,现在90多岁了!”
大家怎么看?
更新于:2024-12-03 22:08
 算命久久网
算命久久网


